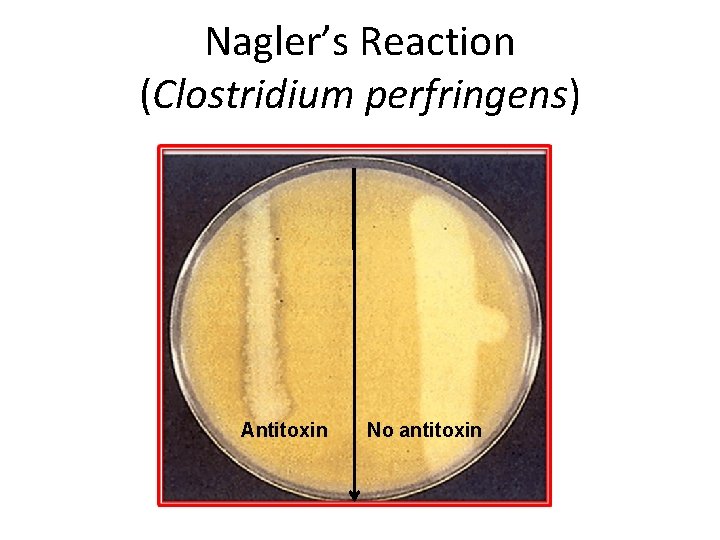
Nagler’s Reaction (Clostridium perfringens) Antitoxin No antitoxin
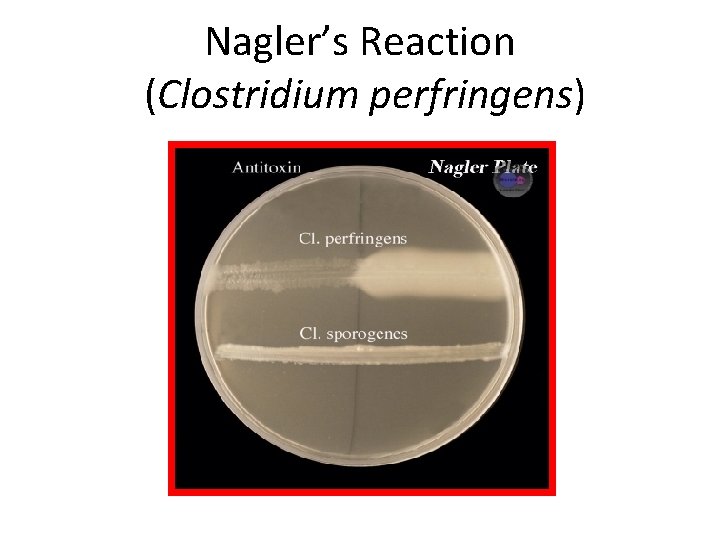
Nagler’s Reaction (Clostridium perfringens)
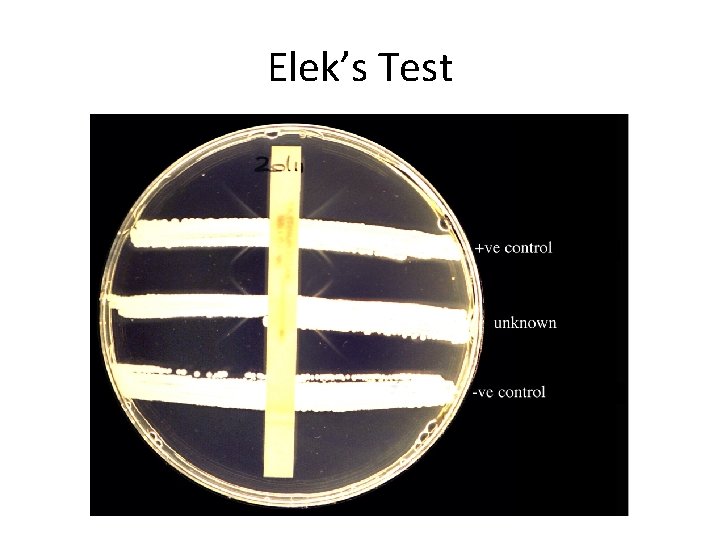
Elek’s Test
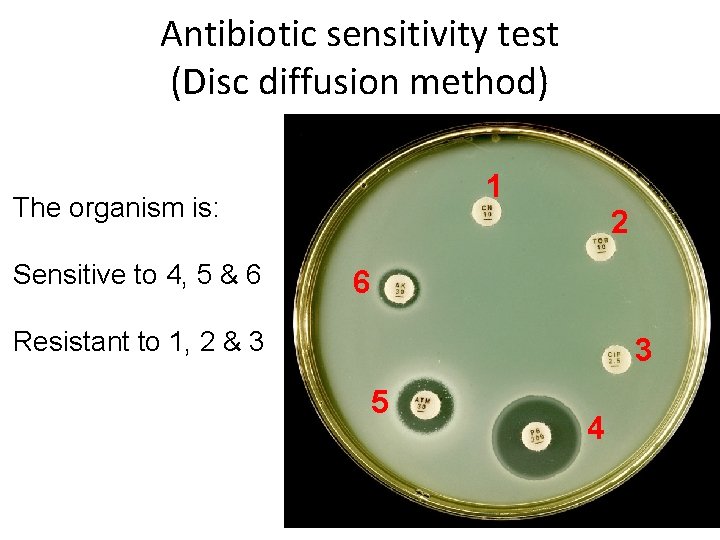
Antibiotic sensitivity test (Disc diffusion method) 1 The organism is: Sensitive to 4, 5
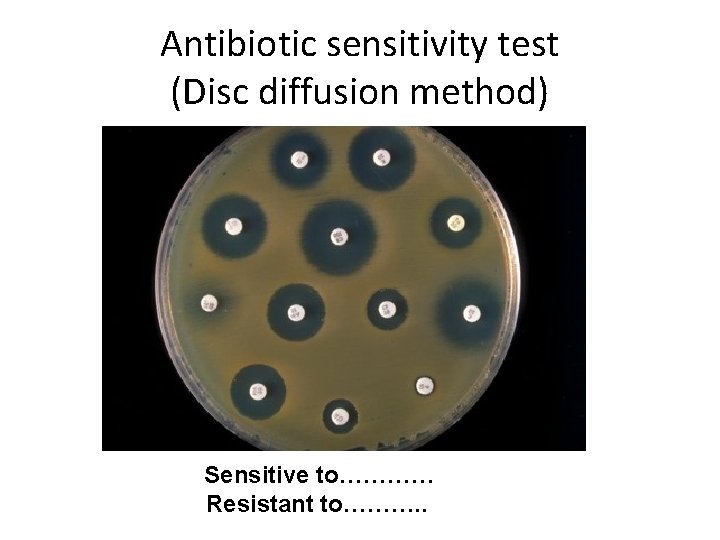
Antibiotic sensitivity test (Disc diffusion method) Sensitive to………… Resistant to………. .
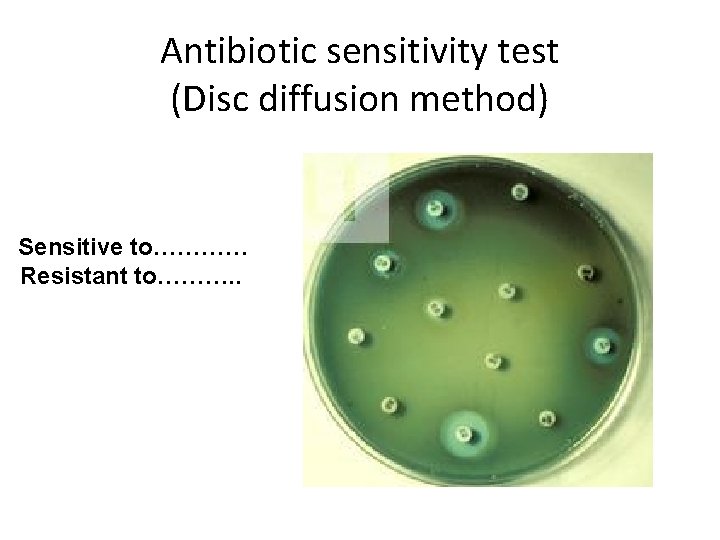
Antibiotic sensitivity test (Disc diffusion method) Sensitive to………… Resistant to………. .
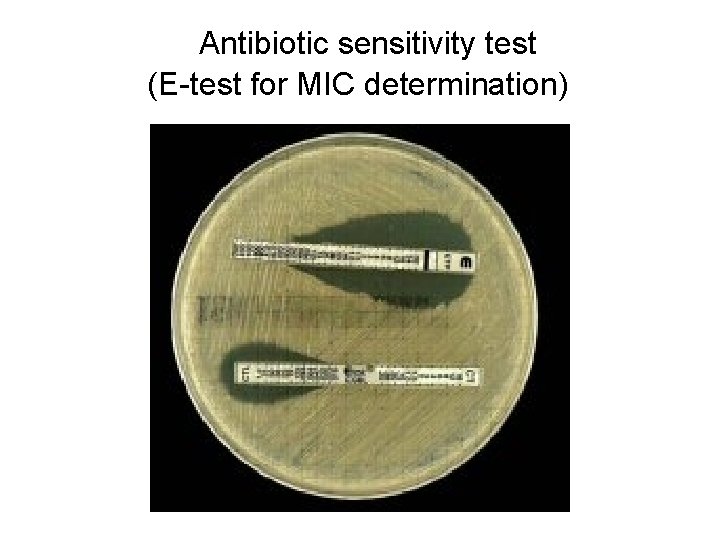
Antibiotic sensitivity test (E-test for MIC determination)
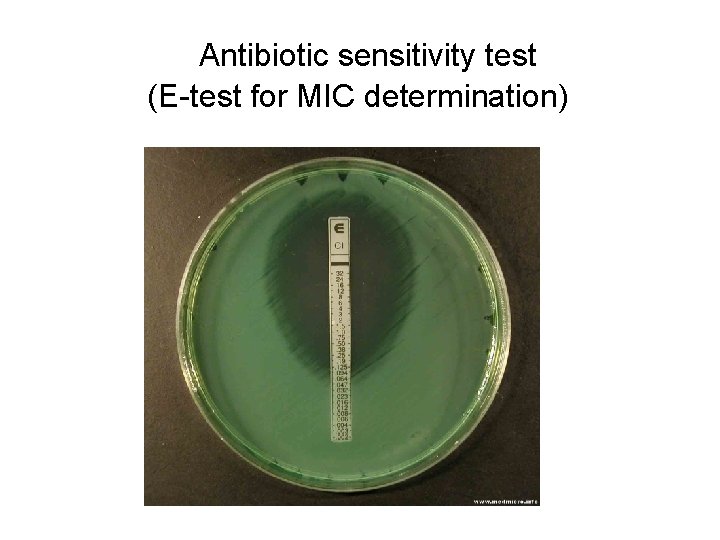
Antibiotic sensitivity test (E-test for MIC determination)
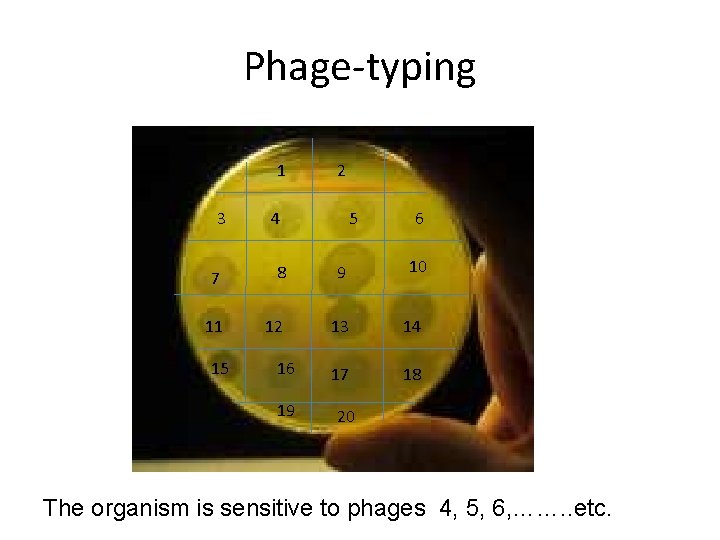
Phage-typing 1 3 2 4 5 6 10 7 8 9 11 12 13
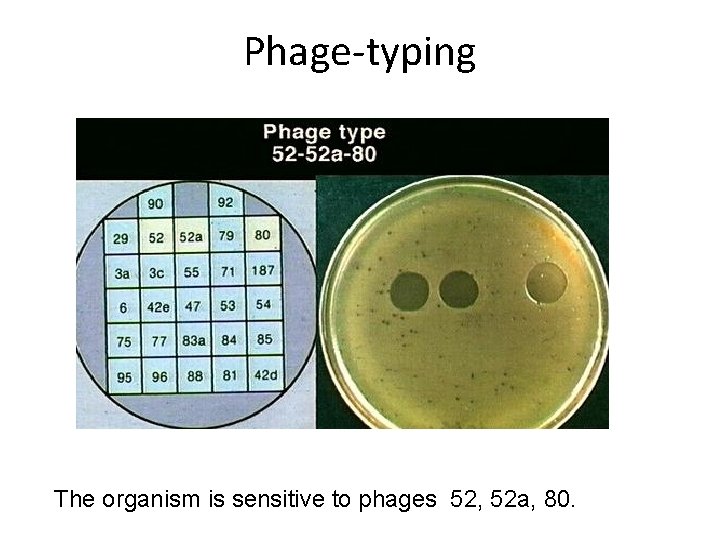
Phage-typing The organism is sensitive to phages 52, 52 a, 80.

Scheme for BIOCHEMICAL REACTIONS Urease test ve ve

Scheme for BIOCHEMICAL REACTIONS

Urease test -ve +ve e. g. Proteus

Catalase Test e. g. Streptococci e. g Staphylococci

Catalase Test e. g. Streptococci e. g Staphylococci

Coagulase Test Staphylococcus aureus Coagulase negative staphylococci, e. g. S. epidermidis

Coagulase test Staphylococcus aureus Coagulase negative staphylococci, e. g. S. epidermidis

Oxidase test Oxidase positive e. g. Neisseria, Pseudomonas

Oxidase test Oxidase positive e. g. Neisseria, Pseudomonas

Oxidase test + ve Oxidase positive e. g. Neisseria, Pseudomonas - ve

Indole test + ve e. g. E. coli - ve e. g. Klebsiella

Indole test

MR & VP tests MR test VP test -ve +ve

Citrate test

Citrate test Citrate positive Citrate negative

B. R. of E. coli Indole I + MR M + VP V - Citrate C - TSI

B. R. of Klebsiella VP I - M - V + C + TSI
Nagler’s Reaction (Clostridium perfringens) Antitoxin No antitoxin
Nagler’s Reaction (Clostridium perfringens)

Analytical Profile Index (API) Biochemical identification system

Analytical Profile Index (API) Biochemical identification system

Analytical Profile Index (API) Biochemical identification system

String Test (Positive in Vibrio cholerae)

String Test (Positive in Vibrio cholerae)

String Test (Positive in Vibrio cholerae)

Scheme for SEROLOgical tests

Tube agglutination test (Titre: 1/320) 1/20 1/40 1/80 1/160 1/320 1/640 TITRE 1/1280 - ve control

Brucella tube agglutination test showing prozone phenomenon (Titre: 1/320) 1/20 1/40 1/80 1/160 1/320 1/640 1/1280 TITRE - ve control

Widal Test (Recent infection with S. Typhi) (Titre: 1/320) 1/20 1/40 O H 1/80 1/160 1/320 1/640 1/1280 C C T H C PA H C PB

Widal Test (Old infection with S. Typhi) 1/20 1/40 O H 1/80 1/160 1/320 1/640 1/1280 C C T H C PA H C PB

Widal Test (Post vaccination) 1/20 1/40 1/80 1/160 1/320 1/640 1/1280 O C H C T H C PA H C PB

Latex Agglutination Test (A: Positive)

Latex agglutination Test (2 & 4: Positive )

Single radial immunodiffusion

Single radial immunodiffusion 1 2 5 6 4 3

Elek’s Test Toxigenic C. diphtheriae Non-toxigenic C. diphtheriae
Elek’s Test

Immunofluorescence

Immunofluorescence

ELISA plate

ELISA plate

ELISA plate

ELISA plate

ELISA plate

Western Blot for diagnosis of HIV

Scheme for miscellaneous tests

Tuberculin Skin Test (TST) Positive
Antibiotic sensitivity test (Disc diffusion method) 1 The organism is: Sensitive to 4, 5 & 6 2 6 Resistant to 1, 2 & 3 3 5 4
Antibiotic sensitivity test (Disc diffusion method) Sensitive to………… Resistant to………. .
Antibiotic sensitivity test (Disc diffusion method) Sensitive to………… Resistant to………. .

Antibiotic sensitivity test (Tube dilution method for MIC determination) MIC
Antibiotic sensitivity test (E-test for MIC determination)
Antibiotic sensitivity test (E-test for MIC determination)
Phage-typing 1 3 2 4 5 6 10 7 8 9 11 12 13 14 17 18 15 16 19 20 The organism is sensitive to phages 4, 5, 6, ……. . etc.
Phage-typing The organism is sensitive to phages 52, 52 a, 80.
- Slides: 54